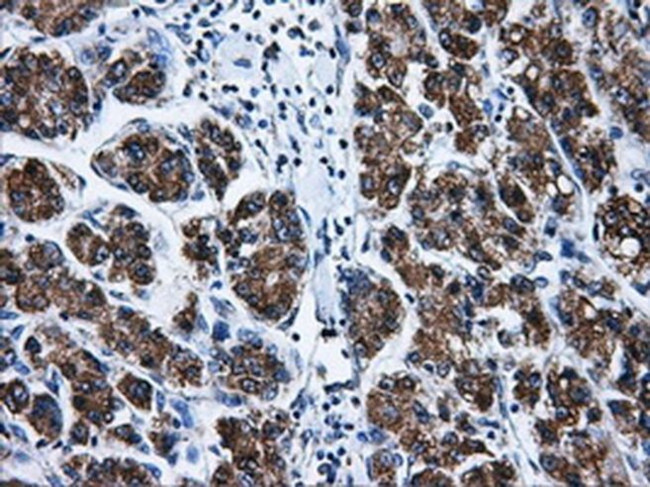
Livin Antibody in Immunohistochemistry (Paraffin) (IHC (P))

Search
Invitrogen
Livin Monoclonal Antibody (OTI1D12)
{{$productOrderCtrl.translations['antibody.pdp.commerceCard.promotion.promotions']}}
{{$productOrderCtrl.translations['antibody.pdp.commerceCard.promotion.viewpromo']}}
{{$productOrderCtrl.translations['antibody.pdp.commerceCard.promotion.promocode']}}: {{promo.promoCode}} {{promo.promoTitle}} {{promo.promoDescription}}. {{$productOrderCtrl.translations['antibody.pdp.commerceCard.promotion.learnmore']}}
图: 1 / 4
Livin Antibody (MA5-25012) in IHC (P)




产品信息
MA5-25012
种属反应
宿主/亚型
分类
类型
克隆号
抗原
偶联物
形式
浓度
规格
纯化类型
保存液
内含物
保存条件
运输条件
RRID
靶标信息
The inhibitor of apoptosis (IAP) family of proteins regulates programmed cell death triggered by various stimuli. All IAPs have at least one baculovirus IAP repeat (BIR) motif that is essential for their anti-apoptotic activity. Recently, it has been identified that a novel human inhibitor of apoptosis protein (IAP) family member termed Livin or ML-IAP, which contains a single baculoviral IAP repeat (BIR) domain and a COOH-terminal RING finger domain. Livin gene has two splicing variants that contain open reading frames of 298 and 280 amino acids and both contained a single copy of baculovirus IAP repeat (BIR) and RING domain. Both of the isoforms inhibit TNFa induced apoptosis in Jurkat cells. Livin expression is low in adult tissues. It is relatively expressed at a higher level in developmental tissues and in many cancer cells.
仅用于科研。不用于诊断过程。未经明确授权不得转售。
篇参考文献 (0)
生物信息学
蛋白别名: Baculoviral IAP repeat-containing protein 7; KIAP; Kidney inhibitor of apoptosis protein; Livin; livin inhibitor of apoptosis; Melanoma inhibitor of apoptosis protein; ML-IAP; RING finger protein 50; RING-type E3 ubiquitin transferase BIRC7; RP11-261N11.7
基因别名: BIRC7; KIAP; LIVIN; ML-IAP; MLIAP; RNF50; UNQ5800/PRO19607/PRO21344
UniProt ID: (Human) Q96CA5
Entrez Gene ID: (Human) 79444